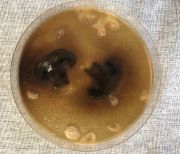

This special page shows all uploaded files.
| Date | Name | Thumbnail | Size | Description | Versions |
|---|---|---|---|---|---|
| 19:08, 30 January 2018 | Puzzle experiment.jpg (file) |  |
77 KB | File uploaded with MsUpload | 1 |
| 11:11, 25 January 2018 | 24.3.jpg (file) | |
832 KB | File uploaded with MsUpload | 1 |
| 11:11, 25 January 2018 | 24.2.jpg (file) |  |
769 KB | File uploaded with MsUpload | 1 |
| 11:11, 25 January 2018 | 24.1.jpg (file) |  |
989 KB | File uploaded with MsUpload | 1 |
| 11:00, 25 January 2018 | 17.d.jpg (file) |  |
236 KB | File uploaded with MsUpload | 1 |
| 11:00, 25 January 2018 | 17.c.jpg (file) |  |
258 KB | File uploaded with MsUpload | 1 |
| 11:00, 25 January 2018 | 17.b.jpg (file) |  |
218 KB | File uploaded with MsUpload | 1 |
| 11:00, 25 January 2018 | 17.a.jpg (file) |  |
263 KB | File uploaded with MsUpload | 1 |
| 10:56, 25 January 2018 | 17.8.jpg (file) |  |
209 KB | File uploaded with MsUpload | 1 |
| 10:54, 25 January 2018 | 17.7.jpg (file) |  |
449 KB | File uploaded with MsUpload | 1 |
| 10:48, 25 January 2018 | 17.2.jpg (file) |  |
220 KB | File uploaded with MsUpload | 1 |
| 10:46, 25 January 2018 | 17.5.jpg (file) |  |
246 KB | File uploaded with MsUpload | 1 |
| 10:46, 25 January 2018 | 17.3.jpg (file) |  |
259 KB | File uploaded with MsUpload | 1 |
| 10:44, 25 January 2018 | 17.1.jpg (file) |  |
276 KB | File uploaded with MsUpload | 1 |
| 10:44, 25 January 2018 | 17.6.jpg (file) |  |
311 KB | File uploaded with MsUpload | 1 |
| 10:44, 25 January 2018 | 17.4.jpg (file) |  |
241 KB | File uploaded with MsUpload | 1 |
| 10:05, 25 January 2018 | 12.5.jpg (file) |  |
357 KB | File uploaded with MsUpload | 1 |
| 10:05, 25 January 2018 | 12.4.jpg (file) |  |
159 KB | File uploaded with MsUpload | 1 |
| 10:05, 25 January 2018 | 12.3.jpg (file) |  |
187 KB | File uploaded with MsUpload | 1 |
| 10:05, 25 January 2018 | 12.2.jpg (file) |  |
568 KB | File uploaded with MsUpload | 1 |
| 10:05, 25 January 2018 | 12.1.jpg (file) |  |
344 KB | File uploaded with MsUpload | 1 |
| 09:54, 25 January 2018 | 10.6.jpg (file) |  |
609 KB | File uploaded with MsUpload | 1 |
| 09:54, 25 January 2018 | 10.5.jpg (file) |  |
524 KB | File uploaded with MsUpload | 1 |
| 09:54, 25 January 2018 | 10.4.jpg (file) |  |
503 KB | File uploaded with MsUpload | 1 |
| 09:54, 25 January 2018 | 10.3.jpg (file) |  |
575 KB | File uploaded with MsUpload | 1 |
| 09:54, 25 January 2018 | 10.2.jpg (file) |  |
564 KB | File uploaded with MsUpload | 1 |
| 09:54, 25 January 2018 | 10.1.jpg (file) |  |
318 KB | File uploaded with MsUpload | 1 |
| 09:30, 25 January 2018 | 8.5.jpg (file) |  |
594 KB | File uploaded with MsUpload | 1 |
| 09:30, 25 January 2018 | 8.4.jpg (file) |  |
458 KB | File uploaded with MsUpload | 1 |
| 09:30, 25 January 2018 | 8.3.jpg (file) |  |
420 KB | File uploaded with MsUpload | 1 |
| 09:30, 25 January 2018 | 8.2.jpg (file) |  |
562 KB | File uploaded with MsUpload | 1 |
| 09:30, 25 January 2018 | 8.1.jpg (file) |  |
571 KB | File uploaded with MsUpload | 1 |
| 09:27, 25 January 2018 | 2.4.jpg (file) |  |
394 KB | File uploaded with MsUpload | 1 |
| 09:27, 25 January 2018 | 2.3.jpg (file) |  |
327 KB | File uploaded with MsUpload | 1 |
| 09:27, 25 January 2018 | 2.2.jpg (file) |  |
362 KB | File uploaded with MsUpload | 1 |
| 09:27, 25 January 2018 | 2.1.jpg (file) |  |
353 KB | File uploaded with MsUpload | 1 |
| 09:24, 25 January 2018 | 23.jpg (file) |  |
413 KB | File uploaded with MsUpload | 2 |
| 09:24, 25 January 2018 | 21.jpg (file) |  |
525 KB | File uploaded with MsUpload | 2 |
| 09:21, 25 January 2018 | 20.1.jpg (file) |  |
311 KB | File uploaded with MsUpload | 2 |
| 09:19, 25 January 2018 | 20.3.jpg (file) |  |
628 KB | File uploaded with MsUpload | 1 |
| 09:19, 25 January 2018 | 20.2.jpg (file) |  |
335 KB | File uploaded with MsUpload | 1 |
| 09:18, 25 January 2018 | 20.5.jpg (file) |  |
309 KB | File uploaded with MsUpload | 1 |
| 09:18, 25 January 2018 | 20.4.jpg (file) |  |
431 KB | File uploaded with MsUpload | 1 |
| 09:12, 25 January 2018 | 15.4.jpg (file) |  |
327 KB | File uploaded with MsUpload | 1 |
| 09:12, 25 January 2018 | 15.3.jpg (file) |  |
303 KB | File uploaded with MsUpload | 1 |
| 09:12, 25 January 2018 | 15.2.jpg (file) |  |
312 KB | File uploaded with MsUpload | 1 |
| 09:12, 25 January 2018 | 15.1.jpg (file) |  |
277 KB | File uploaded with MsUpload | 1 |
| 09:10, 25 January 2018 | 截图.jpg (file) |  |
327 KB | File uploaded with MsUpload | 1 |
| 09:07, 25 January 2018 | 15-12-4.jpg (file) |  |
2.17 MB | File uploaded with MsUpload | 3 |
| 09:07, 25 January 2018 | 15-12-3.jpg (file) |  |
2.15 MB | File uploaded with MsUpload | 3 |